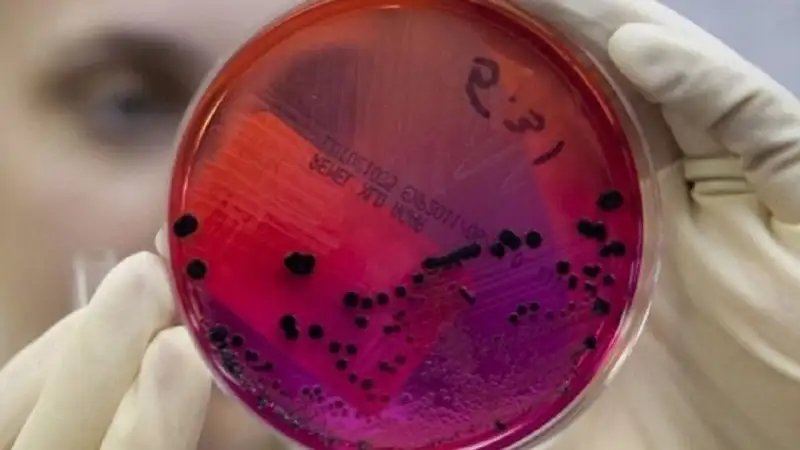

Фейком назвали в МСХ информацию о зараженном сибирской язвой мясе на прилавках
Фото: wikipedia
Фото: wikipedia
В Министерстве сельского хозяйства сообщили, что в селе Ушкарасу Жаркаинского района Акмолинской области накануне была зафиксирована кожная форма сибирской язвы среди населения. Однако сейчас все пациенты находятся под наблюдением медицинских работников, принимают лечение согласно клиническому протоколу.
"В Ушкарасу доставлены более 1,7 тыс. доз вакцин и дезинфицирующие средства. Распространяемая в социальных сетях информация о том, что на прилавки казахстанских рынков попала зараженная сибирской язвой мясная продукция не соответствует действительности. Также ложным является сообщение о наличии очагов сибирской язвы в городе Косшы Акмолинской области", – сказано в сообщении ведомства.
Районным отделом полиции в селе выставлены блокпосты, ограничивающие вывоз сельхозпродукции, объявлен карантин.
Сообщение от директора животноводческого предприятия ТОО "Ушкарасу" о гибели скота поступило 28 августа. Мясо было в оперативном порядке изъято, а павший скот утилизирован, заверяют в МСХ.
"Сейчас в Жаркаинском районе находится рабочая группа из числа работников СЭС, здравоохранения, территориальной инспекции Комитета ветеринарного контроля и надзора, а также Управления ветеринарии. Во всех обследованных очагах проведена дезинфекция, отобраны пробы почвы и грунтовых вод для дальнейшего исследования. В село доставлены более 1,7 тыс. доз вакцин и 900 тыс. мл дезинфицирующих средств, а также вся необходимая для обследования и ликвидации очага спецтехника. На месте работают девять специалистов РГУ "Республиканский противоэпизоотический отряд", – сообщили в МСХ.
Создана специальная комиссия по оценке ущерба и выплате компенсации за павший скот. Ситуация находится под контролем ответственных государственных органов, заключили в МСХ.












